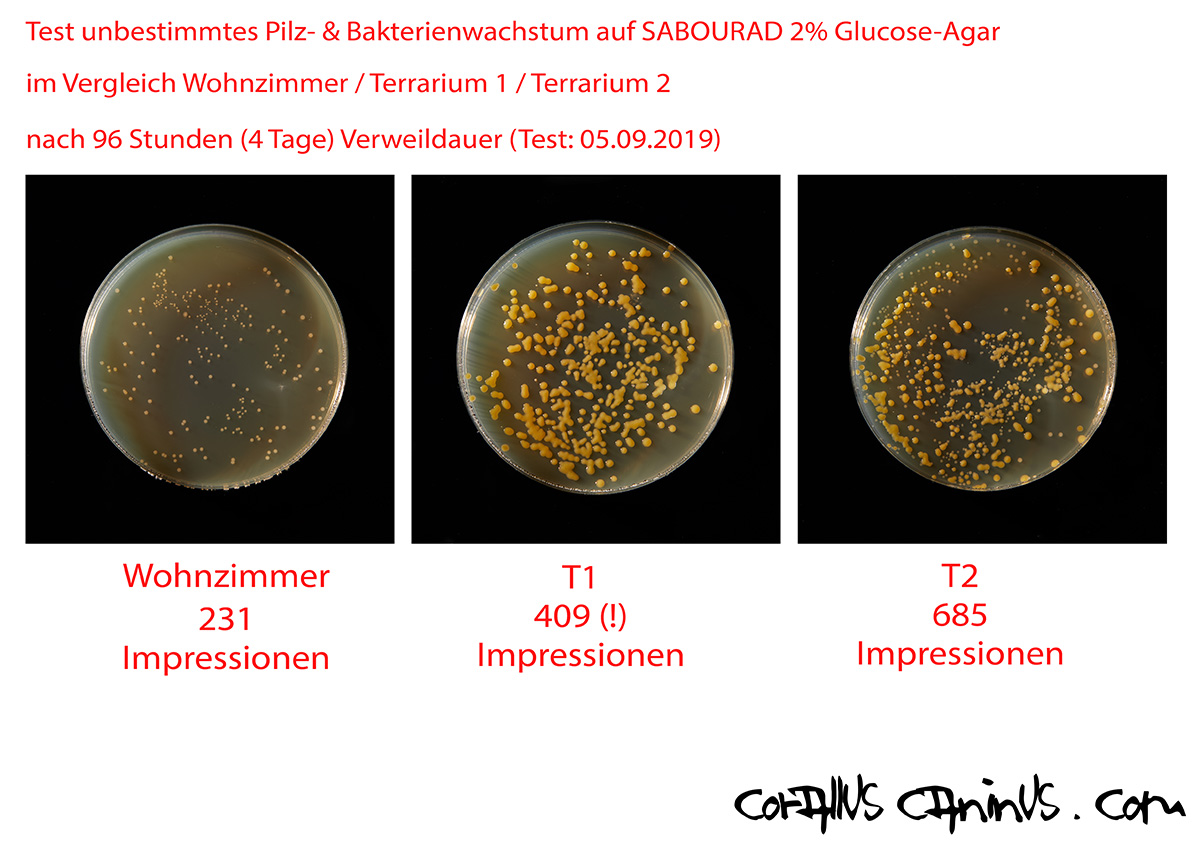

„Eine Schlange macht noch keinen Dschungel!”
Vorraussetzungen & Haltung von Caninus & Batesii
Allgemeines zur Haltung von Corallus caninus
Über die Haltung & zucht dieser wunderschönen Tiere gibt es die unterschiedlichsten Informationen der verschiedensten Züchter und Halter auf der ganzen Welt. Was genau des Pudels Kern hier ist, bleibt offen und gilt es noch heraus zu finden. Von der Art der Terrarien (hoch oder quer), der Bepflanzung (PVC oder echt), der Liegemöglichkeiten (Äste oder Plastik) über das Substrat, die Anbindung des Wassergefässes und und und.
Dennoch, um einen Überblick über die Anschaffungen und Ausstattung zu bekommen, hier die Infos dazu.
Was ich hier an Informationen zusammen getragen habe, ist im wesentlichen das Exzerpt aus Gesprächen mit anderen Haltern und Züchtern, Internetrecherchen und Gelesenem und meinen eigenen Erfahrungen der letzten 10 Jahre.
Über die Jahre hat sich vieles in und um meine Terrarien geändert. Und, obwohl ich aktuell mit meinen letzten Becken sehr zufrieden bin, ist dies sicher immer noch nicht der Weisheit letzter Schluss (für Mich!).
Das Terrarium
Unabhängig dessen, wieviel Platz ein jeder zur Verfügung hat, stellte sich die Frage ob das Terrarium ein Hochformat oder Querformat Becken werden soll. Hier gehen die Meinungen stark auseinander! Die meisten der Corallus caninus oder batesii Besitzer, haben sich für ein Querformat entschieden, wie ich schlussendlich (leider) auch. Dies ist aber leider, so auch bei mmmir, dem vorhandenem Platz im Keller, Terrarienzimmer, Wohnung oder… geschuldet. 2 Terrarien die, beispielsweise 140cm hoch sind, benötigen übereinander mit Unterbau und Überbau schon mindestens 3,2 m in Höhe. Während im Querformat, Becken mit einer Höhe von 100cm plus Unter- und Überbau gut in ein normales Haus oder Zimmer hinein passen würden.
Auch geben einige Züchter an, das der Temperaturverlauf von Oben nach Unten in einem Querformatbecken nicht so dratisch ist! Dies ist auf alle Fälle richtig.
Also beispielsweise bei einem 1,2 m hohem Becken, mit drei, vier oder fünf horizontalen Ästen, können sich die Tiere ihre bevorzugte Temperatur besser auswählen. Da der Temperaturverlauf wesentlich unterschiedlicher ist als in einem Querformat Becken und dies eher natürlich ist, oben nwarm und unten kühl. Da allerdings in einem Querformatbecken meistens auf der einen Seite die Heizung ist und daneben die Lichteinheit, müssen sich die Tiere entscheiden zwischen Wärmequelle, kuschelig warm und “dunkel” oder kühler aber eben unter der Lichtquelle. Meine tiere bevorzugen in der regel “verstecktere” Schlafplätze.
Wenn man allerdings bedenkt, das eine Schlange in Lauerstellung, die gesamt an die 2 m misst, sich an den obersten Ast klammert und dann nach unten hängt, schon gerne mal 60 cm dafür benötigt, ist eine Höhe von 100 cm ein MindestMuss. Ich kenne einige Fotos von sich paarenden Tieren, wo das Ende des Schwanzes der Tiere bereits auf dem Boden aufliegt, was sicher sehr unnatürlich ist. Aber logisch bei einer Beckenhähe von nur 60-80 cm.
Bei einem hohen Terrarium mit Deckenheizung, kann es wiederum zum enormen Temperaturgefälle kommen, was gerade Nachts eine wesentliche Rolle spielt. Hierbei gilt es natürlich zu erwähnen, daß das Temperatur-Gefälle (von oben nach unten) im Wesentlichen von der allgemeinen Raumtemperatur, in denen die Becken stehen, abhängt. Ist der Raum relativ kühl (so etwa 16 Grad) kann das Gefälle von der Decke (Heizer), bei einer Nachttemperatur von 24 Grad, bis zum Boden schon einmal 6 Grad Unterschied betragen. In einem Terrarienzimmer mit durchschnittlich 23 Grad Raumtemperatur sind es dann eben nur noch 1 Grad Unterschied. Das heisst, wenn das Tier in Lauerstellung hängt, befindet sich der Körper bei 24 Grad (Decke) und der Kopf bei etwa 18 Grad! Inwieweit dies konkrete Auswirkungen auf das Wohlbefinden hat, ist nicht näher untersucht. Aber gut ist es sicher nicht.
Meine aktuellsten Becken, in letzter Generation, sind 140×100 cm Quer und 60cm tief!

selbst sind eine geklebte/geschraubte Konstruktion aus 15 mm Kömacell (geschäumter PVC Kunststoff) der sich wunderbar verarbeiten lässt. Sei es bohren, schneiden oder kleben. Auch hat das Material eine relativ gute wärmeisolierende Eigenschaft. Einzigster Wehmutstropfen, das Material ist bei weitem nicht so formstabil wie etwa Holz oder Spanplatten.
Im inneren des Terrariums befinden sich drei Lichtquellen, das Heizelement und eine Sprühdüse. Der Hintergrund & die Seiten, ist gepresster Kork (2cm stark) in dunkelbrauner Farbe, welcher gleichzeitig als Wärmeisolation dient.
in den Becken übernimmt ein Heatpanel von HEKA (zur Jung-Küken-Aufzucht) mit je 70 Watt Leistung, welches direkt oben innen, an der „Decke“ des Terrariums angeschraubt ist. Diese Teile sind unverwüstlich und für wirklich raue Anforderungen gemacht. Und es gibt sie in 4 verschiedenen Größen. Ausserdem sind so bauarttechnisch angelegt, das die meiste Wärmestrahlung nach unten gerichtet ist. Ich hatte in all den Jahren noch keinen einzigen Ausfall dieser Heizer und einer läuft nun schon seit mehr als 15 Jahren täglich. Der Vollständigkeit sei erwähnt, daß sich im Inneren nder Geräte einzig ein Widerstandsdraht befindet der sich aufheitzt. Nicht mehr und nicht weniger. Die Steuerung dafür übernimmt ein „Biotherm Pro“ oder “Microclimate”. Für meine Becken, habe ich mir einen Temperaturverlauf überlegt, der in 8 Schritten die Temperatur über den gesamten Tag unterschiedlich regelt. Für mich persönlich ist es sehr Schade, daß moderne Geräte diese 8 Schaltstufen nicht mehr besitzen und man “gezwungen” ist, den Temperaturverlauf auf 4 Stufen herunter zu brechen. Mir wären mehr als zehn Stufen noch viel lieber. Um einen schönen homogenen Übergang der Temperaturstufen zu erreichen. Über das Jahr verteilt gibt es verschiedene persönliche Temperatur Szenarien um “Sommer” wie “Winter” zu simulieren.
wird mit jeweils eines LED Deckenstrahlers (gibt res quadratisch und rund) umgesetzt, welcher mit einer einfachen elektronischen Zeitschaltuhr gesteuert wird. Ich verwende Warmes Licht um die 3200 Kelvin. In meinen neuesten Becken befindet sich jeweils noch eine UV Röhre, 8 Watt Arcadia “ShadeDweller”. alle drei Lampen steuere ich einzeln an, so daß auch hier ein “Verlauf” möglich ist. Interessante Fakten und Studien zu verschiedensten Leuchten findet Ihr auf der äußerst informativen Website von Sarina Wunderlich “Licht im Terrarium”. Ein wirklich tolles und umfangreiches Kompendium zum Thema Licht im Terrarium. Sehr empfehlenswert!
Ob und wieweit Schlangen, die den dichten Dschungel bewohnen und Ihren Vitamin D Haushalt “gut” über das sehr komplexe Futter (Ratten & Mäuse, Vögel) steuern können, überhaupt UV Licht benötigen, ist auch nicht untersucht.
besteht in meinen Becken für adulte Tiere aus Kokosfaserhumus welches in etwa mit 5 cm Höhe den Boden bedeckt. Sollten die Tiere koten, entferne ich den Bereich großflächig und fülle regelmässig den Bodengrund auf. Alljährlich tausche ich diesen komplett aus.
In meinen Aufzucht & Jungtier Becken nutze ich “Einmal Unterlagen” aus der Humanmedizin oder schlichten Küchenrolle. Der sehr große Vorteil eines Bodens aus “Einmalunterlagen” ist der, das einem wirklich garnichts an minimalem Kot oder Urin entgeht! Gerade Jungtiere geben oftmals, zwischen den Großen Portionen nur sehr sehr kleine Mengen gerade an Urin ab. Nachteil ist das wirklich schrecklich cleane Aussehen! Ich meine auch das Wohlbefinden bei Berührung wenn die Tiere Nachts auf den Boden gehen ist nicht so toll, wie ich finde. Der Kokosfaserboder berarf etwas mehr Kontrolle, hält allerdings länger und der Hauptgrund warum ich ihn verwende ist, das er eben nach Natur und nicht Krankenhaus aussieht!

Einmal Unterlage aus der Humanmedizin, auf Größe geschnitten, in einem meiner juvenilen Becken

Im Vergleich dazu das natürliche Aussehen des Kokosfaser Bodens
bestehen in meinen Terrarien, adult wie juvenil, aus echtem Ästen aus der Natur. Ich empfehle sehr knorpeliges verzwegtes Holz, zb Kirsche. Meine Äste finde ich in alten aufgelassenen Obstgärten, desinfiziere diese gründlich mit Wasserstoffperoxyd, dusche sie heiss ab und lege sie zum trocknen mehrere Wochen zur Seite bis ich sie einbaue.
Baut man seine Äste so ein, das sie schnell “gewechselt” werden können ist dies bei grober Verschmutzung auch von Vorteil. Rausnehmen, desinfizieren, dusche und wieder rein. Oder einmal umdekorieren. Das ist mit Sicherheit auch von großem Vorteil für die Tiere. Oft habe ich gelesen, der Durchmesser sollte in etwa 0,5 x des Durchmessers des Tieres entsprechen. Das würde bei einem ausgewachsenem großen Tier von 2 m Länge, mit einem Durchmesser von knapp 6 cm, etwa 3 cm Dicke entsprechen. Das finde ich persönlich zu dick! Laut meinen Erfahrungen bevorzugen die Tiere in Regel dünnere Äste. Und das würde ich auch jedem empfehlen.

Hier mal ein Foto (am Tag nach dem Fund aufgenommen) der Guyana Expedition mit dem Ast, auf dem wir ein erwachsene Weibchen vorgefunden haben.
In meinem Becken verwende ich gern Kirschäste. Diese sind schön rauh, haben viele Knorpel und sind auch sehr stabil. Plastikstangen etc lehne ich kategorisch ab. Ich kenne Terrarien, die in ihrer Ausstattng (Bodengrund / PVC Rohre / keine Pflanzen / kein natürlicher Bodengrund) der einer sterilen medizinischen Versuchsstation gleichen. Ich kann mir aber nicht vorstellen das die Tiere sich darin wohl fühlen. Nur leider können sie dies nicht mitteilen!
Meine Äste lagern entweder auf angeklebten Korkstücken oder auf selbst hergestellten 3D Druck Asthaltern. Dabei ist zu beachten, das die Äste sich nicht verdrehen können. Ich bewerkstellige dies, meist mit Ästen die Gabelungen haben welche ich dann zu anderen Ästen oder zur Wand fixiere. Das ist besonders bei weiten Becken, um die 120cm und mehr wichtig. Denn hat man in solchen Becken, für adulte Tiere (wir erinnern uns etwa 2 kg), schon seine Mühe haltbare Äste mit zb 2 cm Durchmesser zu finden, welche mit der großen Spannweite das Gewicht von 2 kg abkönnen. Setzt man dann zur Paarungszeit noch ein weiteres Tier dazu, welches sich gern auf denselben Ast gesellt, wird es richtig spannend und unsere Bastelkunst auf die Probe gestellt!

Hier ein tolles Beispiel welchen Astdurchmesser ein adultes Weibchen zum Schlafen bevorzugt und wie “gequält” die Haltung ausschaut
für de von Corallus caninus & Batesii ist auch ein sehr sehr umstrittenes Thema. Während manche Terrarianer fast täglich ihre Tiere Regenwaldmässig mit um die 90% Luftfeuchte halten, bevorzuge ich eher geringere Werte. Was viele aber in diesem Zusammenhang nicht wissen ist, das es auch im tropischen Regenwald recht trockene Phasen gibt. Und vor allem auch sehr sehr unterschiedliche Zonen. Und klar, wenn es geregnet hat, sind unter dem schützenden Blätterdach am Boden gerne über 90% oder mehr Luftfeuchte. Aber nur mal so zum Vergleich. Am Tag des Corallus Fundes im Regenwald von Guyana (März) waren es nicht einmal 50%!!! Auch spielt der Standort innerhalb des Biotopes eine wichtige Rolle. Es gibt einen sehr großen Unterschied zwischen Stellen, zb.: geschützt am Wasser (Fluss oder Bach) im Blätterdach über Boden oder etwas luftiger bei 4 oder 5 Metern Höhe am Rand eines bewaldeten Gebietes. Hier ist noch viel Forschergeist nötig, im Licht ins Dunkel zu bringen.
Ich selbst halte meine Tiere in der Regel zwischen 45-70% Luftfeuchte.
Meines Erachtens, gibt es auch einen großen Nachteil, bei dem in Terrarien herrschenden Mikroklima mit hohen Luftfeuchten. Hier ist die Gefahr von nicht augenscheinlichem Befall von Keimen, Bakterien oder Schimmel gegeben. In der Natur ist ein ständiger Austausch der Luft gegeben und alle Organismen am Boden, in der Luft und auf Steinen und Ästen sind irgendwie aufeinander “abgestimmt”. Das fehlt im MiniMikroKlima unserer Terrarien völlig und dem man nur mit größter Achtung und Sorgsamkeit begegnen kann. Denn bei einem Klima von über 30 Grad Tagsüber und einer Luftfeuchte von über 70%, machen alle möglichen Bakterien, Pilze und Schimmel wahre Freundensprünge über jeden vergessenen biologischen “Abfall”!
Alle meine Terrarien sind mit automatischen Beregnungsanlagen „Lucky Reptile Super Rain SR-1“ die mit einer sekundengenauen Zeitschaltuhr gesteuert werden ausgestattet. Diese dienen für längere gleichmässigere Feuchtephasen und oder hauptsächlich wenn ich dienstlich für mehr als drei Tage mich nicht persönlich kümmern kann. Ansonsten sprühe ich händig mindestens 1 mal pro Tag den Bodengrund.
Obwohl zweifelsfrei und ausser Frage steht, daß die persönliche Betreuung unserer Lieblinge, tägliches Besprühen, Kontrolle etc. die bessere Wahl ist, so ist es nicht jedem vergönnt, jeden Tag Anwesend zu sein um diese Arbeit zu verrichten. Bei mir persönlich war dies von Anfang an eine „Anforderung“ an das Equipment. Alles muss, während eines definierten Zeitraumes auch vollautomatisch funktionieren. Mein Beruf macht es mir leider unmöglich, ausschliesslich jeden Tag alle anfallenden Arbeiten zu übernehmen. Auch ist somit während einer längeren Abwesenheit, Urlaub, für mich die Möglichkeit gegeben, meine Tiere weiter artgerecht und vernünftig zu halten. Diese Entscheidung sollte dennoch jeder Terrarianer für sich selbst und in Ruhe überdenken.
Ich besprühe meine Tiere nur sehr ungern direkt! Warum? Ich habe immer widere feststellen müssen, das die Tiere äusserst schreckhaft auf den plötzlichen “Regen” reagieren. Stellen wir uns doch einmal vor, wir spazieren so vor uns hin und urplötrzlich stehen wir im Regen. In der Natur bei unseren Lieblingen passiert folgendes: Als erstes fällt der Luftdruck rapide ab, einherh´gehend mit einer Verdunkelung. Dann kommt es häufig zu Donnergrollen und erst DANN regnet es. Ich persönlich finde, diese mentale “Vorbereitung” ist wichtig. Habe ich dann einmal diese Wetter Situation hier in Chemnitz vorliegen, kommt das lauwarme Wasser in den Sprüher und ab geht`s.
in meinen Becken besteht fast ausschließlich aus synthetischen Nachbildungen tropischer Hängepflanzen. Diese sind zur Hauptsache aus PVC gefertigt. Die Qualität ist teilweise recht unterschiedlich. Hier müsst Ihr etwas experimentieren um die für Euch am ansprechendsten zu finden. Vor dem Einbringen in das Becken, habe ich meine mit Sterillium desinfiziert und für etwa 1 Stunde in etwa 60 Grad heisses Wasser gelegt (Badewanne) und gründlich durchgespült. Teilweise haben sich Farbpigmente und Plastikfasern aus den „Pflanzen“ gelöst, die dem Charme nichts angetan haben, aber sicher besser für unsere Lieblinge ist.
Einige “Pflanzen” sind mit Wandhaken in der der Decke befestigt und hängen bis fast auf den Boden des Terrariums herab. Und geben so ein schönen Sichtschutz. Andere sind mit Kabelbindern direkt an den Ästen befestigt. Die Pflanzen selbst und die Aufhängung sollten sehr stabil gewählt werden. Fast täglich schlingt sich eines meiner Batesii Männer um eine Ranke und klettert ununterbrochen mit seinem Gewicht von 1,5 kg daran hoch und runter. Dementsprechend sieht diese dann auch aus. Müssen also regelmäßig erneuert werden..

Anfänglich hatte ich auch meine ersten Becken mit echten Kletterpflanzen. Das sah wirklich toll aus und das ganze war eine Freude zum anschauen und geniessen. Der große Nachteil hat sich erst mit der Zeit herausgestellt, als die Pflanzen mit dem Becken so wunderschön “verwuchsen”. Das oft Teile abbrachen, wenn die Tiere mal so wieder richtig “umgegangen” sind, war nicht wirklich störend. Aber da war noch die Hygiene! Falls eine Schlange mal genau “Ziel” mit Ihrem Kot genommen hat, mitten in den Blumentopf sozusagen, war die Reinigung oder Austausch des Erdreiches immer tricky. Vor allem wenn die Pflanzen schon mit dem Terarium “verschmolzen” sind. Und jedesmal hatte ich ein ungutes Gefühl, ob nicht doch vom Kot oder Urin etwas tiefer eingesickert ist und einen Bakterienherd darstellt, der unter Umständen nicht gut für die Gesundheit der Tiere ist. In der Natur ist das natürlich kein Thema. Millionen von Mikroben sorgen hier für ein gutes Gleichgewicht und so ne Portion Schlangenkacka wird um Nu “verputzt” oder in anderes umgewandelt.
Es gibt mittlerweile einige Halter und Züchter mit wirklich tollen NaturTerrarien für Corallus caninus und batesii. Mit “lebendem” Bodengrund und vielen echten Pflanzen. Zu deren praktischen Erfahrungen, Vor und Nachteilen kann ich leider nichts sagen. aber ich weiß, das es funktioniert.
besteht, außer in meinen Aufzuchtbecken, aus 250ml Einweg Polystyrol Behältern, wie sie auch in der Ernährungsmittelbranche eingesetzt werden. Ich habe lange Zeit Behälter aus glattem Keramik verwendet um den Plastikmüll so gering wie nur möglich zu halten. Musste aber feststellen, daß die Reinigung derer (2mal wöchentlich) einen nicht unerheblichen Wasser & Energieverbrauch verursacht.
Der Polystyrol Behälter befindet sich im unteren Drittel des Beckens in einer aus 3D Druck hergestellten Halterung. Aller 3 Tage wechsele ich das Wasser darin und jede Woche wird dieser Becher durch neue ersetzt. In meinen Terrarien für subadulte Tiere verwende ich Glasschalen (IKEA) die es in verschiedenen Dimensionen gibt. Auch hier wird das Wasser alle 3 gewechselt und am Wochenende kommen alle nach einer Oberflächendesinfektion in die Spülmaschine bei 65 Grad. Im Gegensatz zu den Glasschalen, bildet sich in den Plastikbechern schneller ein sogenannter Biofilm (wenn man es mal länger stehen lässt).

Plastikbecher 250 ml mit Eigenbau Halter in Grün
Zum Futter
des Grünen Hundskopfschlingers soie Corallus Batesii gibt es nicht allzu viel Spektakuläres zu sagen und es ist nicht allzu kompliziert.
Die meisten Halter und Züchter füttern Ratten, Weisse oder Farbige Mäuse & Vielzitzenmäuse. Ich selbst kenne niemanden der mit Vögeln seine Tiere füttert. Obgleich immer einmal wieder zu lesen ist, daß die Tiere in Ihrem natürlichen Habitat bevorzugt Vögel fressen würden. Die sehr langen “Fangzähne” und die baumbewohnende Lebensweise sprechen wohl dafür. Wissenschaftliche Belege konnte ich dafür bis Dato nicht finden. Wer hier verlässliche Informationen besitzt, ich wäre sehr an diesen interessiert.
Zu den Diskussionen über das Füttern von lebenden oder toten Futtertieren möchte ich hier nichts beitragen. Es gibt allerdings einige Dinge, die zu beachten sind und die mich beeinflusst haben, auf welche Art und Weise ich persönlich füttere.
Von Geburt an, an tote Futtertiere gewöhnte Schlangen sind sehr unkompliziert. Meine jungen Schlangen, haben immer mal im Wechsel tote und lebende Futtertiere bekommen, was völlig unproblematisch ist. Die Jungen sind ja regelrechte Fressmaschinen vor alllem und voran Corallus batesii. Auch die meisten größeren Schlangen, können problemlos mit beiden gefüttert werden.
Den großen Vorteil, mit lebenden Futtertieren zu füttern ist die Nachahmung des natürlichen Beuteinstinktes der Tiere. Dazu kann man, kurz vor Ende der Lichtperiode am Abend, einen Plastikeimer in die Becken stellen, und nach Einbruch der Dämmerung setzt man mit eine Ratte hinein. Nun kann sich deren Duft in Ruhe im Terrarium verteilen und wird auf natürliche Art und Weise von den Schlangen wahr genommen. Und diese “pirschen” sich meist kurz danach schon langsam heran. Bis sie die optimale “Schussposition” erreicht haben und dann schnappen sie zu. Bei einem toten Futtertier ist das nicht ganz so natürlich. Erstens wird das Tier beim Öffnen des Beckens schon leicht unruhig, weil diese Handlung am Abend sehr ungewohnt ist (sofortiges ändern der Luftfeuchte, Temperatur und das Einströmen von fremden Gerüchen in anderer Intensität ins Becken). Dann halte ich mit einer langen Pinzette, meist kühle ich diese vor etwas herunter, das Futtertier ins Becken damit sich der Duft verbreitet. Mit leichten Bewegungen wird die Schlange zum Zubiss animiert. Was, wenn das Tier hungrig ist, auch sehr oft klappt. Man braucht halt etwas Geduld. Und manchmal sind am Abend auch mehrere Anläufe nötig um den Hunger zu wecken. Ich habe aber auch einige Vielfrasse, die sobald ich die Frontscheibe zur Seite schiebe, sofort mit dem Kopf aus dem Becken kommt, weil er weiss jetzt gibt es gleich was Leckeres. Das ist zwar schön und zugleich amüsant, leider immer recht brachial, wenn das Tier das Futter schnappt und mit aller Gewalt sich dann zurück begibt um sich um die Ratte zu wickeln. Hier ist auch Vorsicht geboten bezüglich der Scheiben – Verletzungsgefahr!!
Ein weiterer Vorteil bei der Fütterung von lebenden Mäusen oder Ratten, ist deren Zustand bezüglich, Vitamine, Proteine und Nährstoffe die noch nicht tiefgefroren wurden und somit sehr natürlich vorliegen. Auch wenn sehr viele Vitamine während des tieffrierens (unter minus 15 C) nicht zerstört werden und sich auch einige Zeit halten, ist es unbestritten, das “frische” Nahrung hier besser ist. Welche Nährstoffe im gefrorenen Zustand genau verloren gehen, ist nicht so leicht zu beantworten. Einige Vitamine halten sich besser, andere eher nicht. Einige Züchter kaufen gefrorene Futtertiere auf Vorrat und bewahren diese oft sehr lange bis es zum verfüttern kommt. Davon halte ich persönlich garnichts. Meine Recherchen über den Verlust der Qualität von “Gefrorenem” haben mich zum Schluss kommen lassen, daß die Futtertiere maximal 2 Monate aufbewahrt werden sollten, bis zum schlussendlichen verfüttern. Bei mir sind das in der Regel 4 Wochen. Das ist aber ein logistisches Problem. Und natürlich auch der Menge der Tiere geschuldet, die man selbst sein eigen nennt.
Ein großer Nachteil des Fütterns mit lebenden Futtertieren, ist je nach Größe, deren eigene Wehrhaftigkeit. Hat die Schlange das Tier nicht optimal ergriffen, kann dieses noch einmal ordentlich zubeißen und der Schlange schweren Verletzungen hinzufügen. Das haben schon einige Züchter am eigenen Leib erfahren müssen. Ratten ab mittlerer Größe (etwa 100 g) und vor allem Vielzitzen Mäuse sind äussert wehrhaft. Dies und die Verfügbarkeit sind sicher der Grund, daß ich meine mal, 95% aller Halter tote Futtertiere verwenden.
Ich dselbst füttere, je nach “Verfügbarkeit” meiner FuttertierZucht zu 75 % mit toten, aufgetauten Ratten und etwa 25 % frischtote Tiere. Bei der Massentierhaltung von Futtertieren (Ratten & Mäusen) stelle ich mir auch immer die Frage wie diese gehalten werden. Besonders im Bezug auf die Verabreichung von Medikamenten, Antibiotika etc… Ich habe nicht so recht Vertrauen in diese Haltung von Ratten und Mäusen für Futterzwecke, auch wenn sehr viele Halter damit gute Erfahrungen gemacht haben. Meine eigenen Ratten sind hundert Prozent Bio, ich kenne deren Haltung und bestimme das Futter, welches auch zu hundert Prozent Bio ist. Das gibt mir ein sehr gutes Gefühl und ich denke, daß die Ratten so ein “glückliches” Leben haben und eine optimale Grundlage als Futter für meine Lieblinge darstellen. PS: Wer einmal gekaufte gefrorene Ratten mit selbst gezüchteten gefrorenen Ratten auftaut vergleicht, weiss wonvon ich spreche. Fleisch versus Waschlappen!!!
Erwartet man eine Nachzucht ist es sehr ratsam lebende Futtertiere in Vorrat zu besitzen, da die Youngster am Anfang oft nur lebend fressen, jedenfalls die ersten zwei drei Mahlzeiten.
Am produktivsten in der Vermehrung sind ganz klar die Vielzitzenmäuse. Hat, oder erwartet man einen Wurf Corallus, kann es von Vorteil sein, sich einen Ansatz Vielzitzenmäuse zu besorgen. 3 zu 1 ist ein gutes Verhältniss. Der Vorteil bei VZM (Vielzitzenmäuse) ist, daß die jungen an mehreren Müttern gesäugt werden. Der Wurf bedeutend größer als bei normalen Mäusen ist und man so mehr Futtertiere zur Verfügung hat. VZM sind nicht so leicht zu händeln. Sie können zum Beispiel nicht einfach am Schwanz angefasst werden, da sie in der Lage sind, an sich selbst hoch zu kriechen und dann wehrhaft zu beissen. Pinzette ist also angesagt. Ich selbst habe in den letzten Jahren aufgrund der Wehrhaftigkeit auf Farbmäuse umgestellt. Sind die Corallus groß genug kann man auf Ratten umsteigen.
Über die Ratten selbst:
Ratten sind sehr leicht zu halten und zu vermehren. Sie machen auch Spaß in der Haltung und Vermehrung. Man kann die hiesige Futterindustrie unterstützen und “hochwertiges” spezielles & teures Rattenfutter kaufen und verfüttern. Ich selbst verfüttere ganz einfache Pellets für Mäuse als “trocken” Grundlage. Sehr preiswert, der Sack mit 25 kg kostet hier etwa 25 €. Dazu Maiskörner (vom Bauern), eine Körnermischung und die Hauptsache bilden Küchenreste (Kartoffelschalen, Kartoffeln, Obst, Gemüse, Wurstreste, Fleischrest etc..) Dazu Wasser aus einem Spender. Seit ich Ratten züchte, gibt es keinen Bioabfall mehr in meinem Haushalt. Und den Tieren geht es prächtig.
Der Nachteil bei Ratten ist, sie sind nicht sehr produktiv. In der Regel sind es etwa 14 Jungtiere pro Wurf. Allerdings nimmt dies nach 2-3 Würfen ab. Die Lebenserwartung liegt auch nur bei maximal 3 Jahren. Man sollte also immer beachten Jungtiere zur weiteren Zucht zurück zu halten. Und um Inzucht zu vermeiden, tausche oder kaufe ich immer mal neue, andere Tiere hinzu. Das funktioniert seit mehreren Jahren wunderbar. Ratten sind gesellige Tiere und sollten nicht allein gehalten werden.
